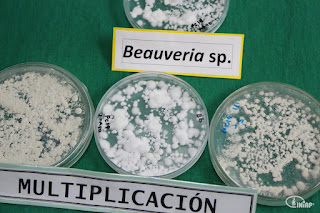

|
Este sitio nos permite escribir, publicar y difundir artículos o boletines relacionados con la actualidad que se vive el día a día en nuestro país ECUADOR.
sábado, 5 de octubre de 2013
Después de festejar la cacería del zorro, aliméntate como en casa
miércoles, 18 de septiembre de 2013
Desde la Granja - Moras de Castilla Guayaba Naranjilla
|
viernes, 10 de mayo de 2013
SEMINARIO SOBRE CONSERVACIÓN, MANEJO Y USO DE LOS RECURSOS FITOGENÉTICOS SE REALIZARÁ EN IBARRA
Quito 10 de mayo de 2013
Estimados compañeros y compañeras comunicadores.
El Instituto Nacional Autónomo de Investigaciones Agropecuarias, INIAP, la Pontificia Universidad Católica del Ecuador, PUCE, Sede Ibarra y la Secretaría Nacional de Educación Superior, Ciencia, Tecnología e Innovación, SENESCYT, realizarán un Seminario sobre Conservación, Manejo y Uso de los Recursos Fitogenéticos, el 14 y 15 de mayo, del presente año, en el Aula Magna de la PUCE, en la ciudad de Ibarra.
Agradecemos la difusión de esta información
Atentamente
--
Lic. Gerardo Heredia
Coordinación de Comunicación del INIAP
gheredia48@gmail.com
gerardo.heredia@iniap.gob.ec
Tel: 2565-939
QUITO - ECUADOR
Siganos en :
 @INIAPECUADOR
@INIAPECUADOR  INIAP ECUADOR INIAP
INIAP ECUADOR INIAP  INIAP ECUADOR
INIAP ECUADORjueves, 9 de mayo de 2013
INIAP DIO A CONOCER RESULTADOS SOBRE INVESTIGACIONES REALIZADA EN CONTROL BIOLÓGICO DE PLAGAS
Quito 9 de mayo de 2013
Estimados compañeros y compañeras comunicadores.
El Instituto Nacional Autónomo de Investigaciones Agropecuarias, INIAP, realizó la presentación de resultados del Proyecto LADAF/NZAID/ INIAP/ AgResearch de Nueva Zelanda "Implementación del Control Biológico para mejorar la calidad de vida de los pequeños agricultores de los Andes ecuatorianos" y la inauguración del laboratorio de Control Biológico ubicado en la Estación Experimental Santa Catalina.
Este proyecto tuvo como objetivo la generación de tecnología para mejorar la calidad y la formulación de organismos benéficos que puedan ser utilizados por los pequeños agricultores en el control de plagas y enfermedades.
Agradecemos la difusión de esta información
Atentamente
--
Lic. Gerardo Heredia
Coordinación de Comunicación del INIAP
gheredia48@gmail.com
gerardo.heredia@iniap.gob.ec
Tel: 2565-939
QUITO - ECUADOR
Siganos en :
 @INIAPECUADOR
@INIAPECUADOR  INIAP ECUADOR INIAP
INIAP ECUADOR INIAP  INIAP ECUADOR
INIAP ECUADORlunes, 6 de mayo de 2013
AGRICULTORES OBSERVARON LOS BENEFICIOS DEL USO DE MICROORGANISMOS BENÉFICOS PARA EL CONTROL DEL GUSANO BLANCO DE LA PAPA
Quito 6 de mayo de 2013
Estimados compañeros y compañeras comunicadores.
El Instituto Nacional Autónomo de Investigaciones Agropecuarias, INIAP, con el apoyo del Gobierno Nueva Zelanda, a través del proyecto denominado, "Uso de microorganismos benéficos para la agricultura", realizó un día de campo en la comunidad La Delicia, parroquia San Juan, provincia de Chimborazo, con el fin de presentar los resultados del trabajo realizado durante 4 años, en el control del gusano blanco de la papa, utilizando microorganismos como la Bauveria sp,
Agradecemos la difusión de esta información
Atentamente
--
Lic. Gerardo Heredia
Coordinación de Comunicación del INIAP
gheredia48@gmail.com
gerardo.heredia@iniap.gob.ec
Tel: 2565-939
QUITO - ECUADOR
Siganos en :
 @INIAPECUADOR
@INIAPECUADOR  INIAP ECUADOR INIAP
INIAP ECUADOR INIAP  INIAP ECUADOR
INIAP ECUADORsábado, 4 de mayo de 2013
viernes, 3 de mayo de 2013
INVITACIÓN
Quito 3 de mayo de 2013
Estimados compañeros y compañeras comunicadores.
El Instituto Nacional Autónomo de Investigaciones Agropecuarias, INIAP, se complace en invitar a Ud., a la presentación de resultados del Proyecto LADAF/NZAID/INIAP/ AgResearch, "Implementación del Control Biológico para mejorar la calidad de vida de los pequeños agricultores de los Andes ecuatorianos" y a la inauguración del laboratorio de Control Biológico, que se realizará en la Estación Experimental Santa Catalina, el 7 de mayo del presente año, a las 10H00.
A través de este proyecto se ha logrado incrementar la capacidad técnica ecuatoriana en temas de control biológico de insectos y enfermedades.
Se dispone de un laboratorio equipado y personal técnico capacitado para realizar actividades de prospección, aislamiento, multiplicación, y pruebas de eficiencia de microorganismos benéficos, así como también la producción, formulación y evaluación de la calidad de productos biológicos; técnicas que permitirán apoyar a instituciones del sector público y privado.
Contamos con su presencia
Atentamente
--
Lic. Gerardo Heredia
Coordinación de Comunicación del INIAP
gheredia48@gmail.com
gerardo.heredia@iniap.gob.ec
Tel: 2565-939
QUITO - ECUADOR
Siganos en :
 @INIAPECUADOR
@INIAPECUADOR  INIAP ECUADOR INIAP
INIAP ECUADOR INIAP  INIAP ECUADOR
INIAP ECUADORjueves, 2 de mayo de 2013
CURSO SOBRE AGENTES MICROBIOLÓGICOS PARA EL CONTROL DE PLAGAS REALIZARÁ EL INIAP Y LA ESPOCH
CURSO SOBRE AGENTES MICROBIOLÓGICOS PARA EL CONTROL DE PLAGAS REALIZARÁ EL INIAP Y LA ESPOCH
Quito 2 de mayo de 2013
Estimados compañeros y compañeras comunicadores
Un curso teórico-práctico internacional sobre el Desarrollo de Agentes Microbiológicos para el Control de Plagas se realizará del 6 al 17 de mayo del presente año organizado por el INIAP, la Escuela Superior Politécnica de Chimborazo, ESPOCH, y el proyecto denominado "Uso de microorganismos benéficos para la agricultura", del Gobierno de Nueva Zelanda.
Este curso se realizará en el Auditorio de la Facultad de Recursos Naturales y Laboratorio de Ciencias Biológicas de la ESPOCH, ubicada en el kilómetro 1,5 de la panamericana Sur, en Riobamba.
Agradecemos la difusión de esta información
Atentamente
--
Lic. Gerardo Heredia
Coordinación de Comunicación del INIAP
gheredia48@gmail.com
gerardo.heredia@iniap.gob.ec
Tel: 2565-939
QUITO - ECUADOR
Siganos en :
 @INIAPECUADOR
@INIAPECUADOR  INIAP ECUADOR INIAP
INIAP ECUADOR INIAP  INIAP ECUADOR
INIAP ECUADORlunes, 29 de abril de 2013
INIAP PARTICIPÓ EN LA FERIA QUE SE REALIZÓ CON MOTIVO DE EL DÍA DE LA PROPIEDAD INTELECTUAL
Quito 29 de abril de 2013
Estimados compañeros y compañeras comunicadores
El Instituto Nacional Autónomo de Investigaciones Agropecuarias, INIAP, participó en la Feria Informativa realizada por el Instituto Ecuatoriano de Propiedad Intelectual, IEPI, en la Plaza de San Francisco de la ciudad de Quito, el 26 de abril del presente año, con motivo de la celebración de "El Día de la Propiedad Intelectual".
Agradecemos la difusión de esta información
Atentamente
--
Lic. Gerardo Heredia
Coordinación de Comunicación del INIAP
gheredia48@gmail.com
gerardo.heredia@iniap.gob.ec
Tel: 2565-939
QUITO - ECUADOR
Siganos en :
 @INIAPECUADOR
@INIAPECUADOR  INIAP ECUADOR INIAP
INIAP ECUADOR INIAP  INIAP ECUADOR
INIAP ECUADORviernes, 26 de abril de 2013
INIAP REALIZÓ EL I SEMINARIO SOBRE EL MANEJO DEL CULTIVO DE NARANJILLA
Quito 26 de abril de 2013
Estimados compañeros y compañeras comunicadores
El Instituto Nacional Autónomo de Investigaciones Agropecuarias, INIAP, en coordinación con el Gobierno Provincial de Santo Domingo de los Tsáchilas, el Ministerio de Agricultura, Ganadería, Acuacultura y Pesca, MAGAP, y la empresa PILVISA, realizó el "I Seminario Taller: Tecnologías para el Manejo Ecológico del Cultivo de Naranjilla", realizado en el recinto Las Mercedes, en la provincia de Santo Domingo de los Tsáchilas.
Agradecemos la difusión de esta información
Atentamente
--
Lic. Gerardo Heredia
Coordinación de Comunicación del INIAP
gheredia48@gmail.com
gerardo.heredia@iniap.gob.ec
Tel: 2565-939
QUITO - ECUADOR
Siganos en :
 @INIAPECUADOR
@INIAPECUADOR  INIAP ECUADOR INIAP
INIAP ECUADOR INIAP  INIAP ECUADOR
INIAP ECUADORDiseño y confección de ropa a su medida
|